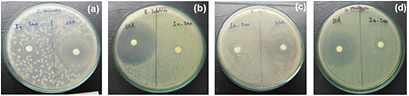
Figure 6.
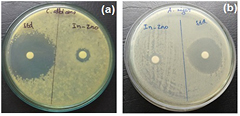
Figure 8.

Abstract
In this work we aim to synthesize biocompatible ZnO nanoparticles from the zinc nitrate via green process using leaf extracts of the Costus pictus D. Don medicinal plant. FTIR studies confirm the presence of biomolecules and metal oxides. X-ray diffraction (XRD) structural analysis reveals the formation of pure hexagonal phase structures of ZnO nanoparticles. The surface morphologies of ZnO nanoparticles observed under a scanning electron microscope (SEM) suggest that most ZnO crystallites are hexagonal. EDX analysis confirms the presence of primarily zinc and oxygen. TEM images show that biosynthesized zinc oxide nanoparticles are hexagonal and spherical. The plausible formation mechanisms of zinc oxide nanoparticles are also predicted. The biosynthesized zinc oxide nanoparticles exhibit strong antimicrobial behavior against bacterial and fungal species when employing the agar diffusion method. Synthesized ZnO nanoparticles exhibit anticancer activity against Daltons lymphoma ascites (DLA) cells as well as antimicrobial activity against some bacterial and fungal strains.
Export citation and abstract BibTeX RIS

Original content from this work may be used under the terms of the Creative Commons Attribution 3.0 licence. Any further distribution of this work must maintain attribution to the author(s) and the title of the work, journal citation and DOI.
1. Introduction
Green synthesis nanoparticle production through plants, bacteria, fungi, and algae allows for the large-scale production of metal oxide particles free of impurities [1]. Different physical and chemical processes are now widely used to synthesize metal oxide nanoparticles, allowing one to obtain particles with desired characteristics. Such manufacturing methods are typically costly and labor-intensive and can be hazardous to the environment and to living organisms. Thus, there is a need for an alternative, cost-effective, safe and environmentally sound means of nanoparticle creation [2–4]. Of the various metal oxide nanoparticles that exist, zinc oxide nanoparticles have attracted the attention of many researchers owing to their various applications to the electronics, communications, sensor, cosmetics, environmental protection, biological and medicinal industries [5–9]. Some plant components, such as roots, leaves, stems, seeds, and fruits, have also been used for zinc oxide nanoparticles synthesis, as plant extracts are rich in phytochemicals, which act as reducing and stabilization agents [10–16]. Some plant leaf extracts used to synthesize zinc oxide nanoparticles include azadirachta indica [17], agathosma betulina [18], aloe vera [19], parthenium hysterophorus L. [20], plectranthus amboinicus [21], vitex negundo L. [22], and pongamia pinnata [23]. Green synthesized zinc oxide nanoparticles exhibit multifunctional behaviors and dynamic antibacterial activity [24]. Feris and colleague show that ZnO nanoparticles exhibit high levels of antibacterial and antifungal activity even at lower concentrations [25]. Several biosynthesized metal applications to biomedical and antimicrobial areas have been explored owing to their biocompatibility [26, 27]. Currently, researchers largely focus on the greener synthesis of ZnO nanoparticles with a particular focus on cancer therapy treatments [28–30].
Costus pictus D. Don, which is commonly known as fiery costus, spiral ginger, step-ladder and the insulin plant, is native to South and Central America [31]. The plant is used in India as an herbal cure for diabetes and hence it is commonly referred to as the 'insulin plant' [32]. Several antidiabetic studies have been carried out on Costus pictus leaf extracts [33]. From the literature we found that only metal (Ag) nanoparticles have been biosynthesized using Costus pictus leaf extracts [34]. The plant-mediated synthesis of nanoparticles is more stable and efficient than that of other organisms. Nanoparticle interactions with biomolecules and microorganisms constitute a broad area of research that has still been largely unexplored. In the present investigation, a green chemistry synthesis of ZnO nanoparticles is carried out using Costus pictus leaf extracts via Fourier-transform infrared (FTIR) spectroscopy, x-ray diffraction (XRD), scanning electron microscope (SEM), energy-dispersive x-ray (EDX) spectroscopy, transmission electron microscopy (TEM) and selected area electron diffraction (SAED) analyses. Biosynthesized ZnO nanoparticles were tested against two gram positive bacteria (Staphylococcus aureus, Bacillus subtilis), two gram negative bacteria (Escherichia coli, Salmonella paratyphi) and two fungal species (Aspergillus niger, Candida albicans) under laboratory conditions. The anticancer activity of the synthesized ZnO nanoparticles was tested against Daltons lymphoma ascites (DLA) bearing mice of a cell line.
2. Materials and methods
2.1. Plant materials collection and preparation
Zinc nitrate (Zn(NO3)2.6H2O) was purchased from Merck Chemicals Ltd, India and was used as received without further purification. Leaves of Costus pictus D. Don were rinsed thoroughly under running water and were then cut into small pieces. The leaves were placed in a circulating oven at 50 °C until they were fully dried. Approximately 2 g of dried Costus pictus plant extract was boiled in double-distilled water for 15 min. The extract obtained was filtered through Whatman no. 1 filter paper and the filtrate was poured into a 250 ml Erlenmeyer flask and stored in a refrigerator for further use.
2.2. Synthesis of ZnO nanoparticles
ZnO nanoparticles were successfully synthesized using plant leaf extracts by adopting the above procedure with slight modifications [20]. We prepared 0.1 M of Zn(NO3)2·6H2O in 50 ml of double-distilled water, and then 10 ml of Costus pictus extract was slowly added drop wise into the solution under magnetic stirring at 80 °C for roughly 4 h to obtain a complex formation. The complex formed after stirring was collected by centrifugation at 10 000 rpm for 10 min. Then, the centrifuge complex was rinsed with water and then subjected to centrifugation at 5000 rpm for 10 min. The separated complex was dried in an oven at 40 °C for 8 h and was then calcined in a muffle furnace at 450 °C to obtain biosynthesized ZnO nanoparticles.
2.3. Characterization
The biosynthesized ZnO nanoparticles were analyzed using the following techniques. An FTIR analysis was carried out using a Nicolet 520P FTIR spectrometer set to 500–4000 cm−1. A powder XRD analysis of ZnO nanoparticles was carried out on a PANalytical x-ray diffractometer operated at 40 kV with a current of 30 mA under Cu-Kα radiation of a 2θ range of 10–80°. SEM images were recorded using a JEOL JSM 6390 system. An energy dispersive spectroscopy (JED 2300, JEOL) analysis was applied to the prepared samples for qualitative elemental analysis. Transmission electron microscopic images were obtained using a transmission electron microscope (CM 200; Philips, USA).
2.4. Antimicrobial activity
The disc diffusion method was applied to examine antimicrobial activity [35]. Ciprofloxacin and fluconazole were taken as a standard for antimicrobial activity. A panel of 6 common pathogenic microorganisms with two gram positive bacteria S. aureus (NCIM 2079), B. subtilis (NCIM 2063) and two gram negative bacteria E. coli (NCIM 2065), S. paratyphi (NCIM 2501) and two fungi strains C. albicans (MTCC 3100) and A. niger (MTCC 1344) was used. Bacterial and fungal strains were obtained from the Kovai Medical College and Hospital in Coimbatore, Tamil Nadu, India.
2.5. Anticancer activity
The ZnO nanoparticles were identified using the standard trypan blue dye inclusion method [36]. Samples with different concentrations (10, 20 and 50 µg) of ZnO nanoparticles were studied over short periods of in vitro cytotoxicity using Dalton's ascites cells (DLA). Tumor cells aspirated from the peritoneal cavity of the tumor-bearing mice were washed three times with phosphate buffered saline (PBS). Cell viability levels were determined via the trypan blue exclusion method. Various concentrations of the test compounds and cell suspension were added, and then the volume was increased to 1 ml using PBS. A control tube contained a cell suspension. The assay mixtures were incubated for 3 h at 37 °C. The cell suspension was mixed with 0.1 ml of 1% trypan blue and was stored for 2–3 min and loaded onto a haemocytometer. Dead cells took on a trypan blue color while live cells did not absorb the dye. The number of stained and unstained cells was measured. The study was carried out at the Amala Cancer Research Center in Amala Nagar Thrissur, Kerala, India. The cytotoxicity percentage is calculated using the following formula as follows

where Nd is number of dead cells, Nl is number of live cells.
3. Results and discussion
3.1. FTIR spectral analysis
Figure 1 shows the FTIR spectrum of bio-synthesized zinc oxide nanoparticles using Costus pictus leaf extracts. FTIR measurements were collected to find biomolecules for capping and for the proficient stabilization of the metal oxide nanoparticles synthesized by Costus pictus leaf extracts. The FTIR spectrum of zinc oxide nanoparticles absorbs at 441.51–665.50 cm−1. The O–H stretch appears in the spectrum as a very broad band extending from 3372.37 cm−1. This very broad O–H stretch band is observed with a C=O peak, which almost certainly indicates that the compound is an aliphatic carboxylic acid. Two peaks attributed to C–F stretching at 1112.64 cm−1 constitute mono- and poly-fluorinated compounds. Moderate levels of absorption in the region covering 1468.12–1384.65 cm−1 imply the presence of an aromatic ring. An absorption peak found at 1047.70 cm−1 corresponds to saturated primary alcohol C–O stretching. Prominent levels of doublet absorption observed at 2337.85–2427.51 cm−1 reveal the presence of C–H stretching vibrations of an aromatic aldehyde. The band observed at 1590.61 cm−1 corresponds to the carbonyl group of flavonoids. Our FTIR analysis confirms that phenolic compounds in flavonoids are better able to bind to metal, indicating that a phenolic group may form metal nanoparticles to prevent agglomeration and to thereby stabilize a medium. This suggests that biological molecules may perform dual functions in forming and stabilizing zinc oxide nanoparticles in an aqueous medium. Gnanasangeetha and colleagues found the formation and stabilization of zinc oxide nanoparticles due to the presence of terpenoids present in plant extracts azadirachta and emblica [37]. In this work, aglycone steroids may have played a major role in stabilizing and capping zinc oxide nanoparticles.
Figure 1. FTIR spectra of ZnO nanoparticles.
Download figure:
Standard image High-resolution image3.2. X-ray diffractometer
Figure 2 shows the x-ray diffraction (XRD) spectrum of the biosynthesized zinc oxide nanoparticles. The main peaks found correspond to Bragg reflections with 2θ values of 31.74°, 34.38° 36.21°, 47.49°, 56.54°, 62.86°, 66.43°, 67.89°, 68.99°, 72.76°, 76.94°, 81.32°, and 89.56°. Locations of the characteristic Bragg reflections were indexed to (1 0 0), (0 0 2), (1 0 1), (1 0 2), (1 1 0), (1 0 3), (2 0 0), (1 1 2), (2 0 1), (0 0 4), (2 0 2), (1 0 4) and (2 0 3) planes of ZnO hexagonal phase structures, respectively, (standard JCPDS card 36-1451) and this confirms the presence of zinc oxide nanoparticles. The XRD pattern observed confirms the absence of other impurities. Table 1 shows the calculated crystallite sizes and lattice strain values for ZnO nanoparticles found based on Debye Scherer's formula, which can be given as

where D is the average crystallite size, β denotes line broadening in radians, θ is the Bragg angle, and λ is the x-ray wavelength. The average crystallite size observed from the intense plane of (1 0 1) was measured as 29.11 nm. XRD patterns obtained through this study are similar to XRD patterns obtained for biologically synthesized ZnO nanoparticles [38].
Table 1. Crystallite size and lattice strain values of ZnO nanoparticles derived using the XRD method.
| 2θ (°) | Crystallite size (nm) | Lattice strain |
|---|---|---|
| 31.74 | 28.77 (1 0 0) | 0.0046 |
| 34.38 | 28.96 (0 0 2) | 0.0042 |
| 36.21 | 29.11 (1 0 1) | 0.0040 |
| 47.49 | 30.23 (1 0 2) | 0.0030 |
| 56.54 | 31.41 (1 1 0) | 0.0024 |
| 62.86 | 32.42 (1 0 3) | 0.0021 |
| 66.43 | 33.07 (2 0 0) | 0.0020 |
| 67.89 | 33.35 (1 1 2) | 0.0019 |
| 68.99 | 33.57 (2 0 1) | 0.0019 |
| 72.76 | 34.36 (0 0 4) | 0.0018 |
| 76.84 | 35.33 (2 0 2) | 0.0016 |
| 81.32 | 36.47 (1 0 4) | 0.0015 |
| 89.56 | 38.97 (2 0 3) | 0.0013 |
Figure 2. XRD spectra of ZnO nanoparticles.
Download figure:
Standard image High-resolution image3.3. SEM and EDX analyses
Raut et al have found a hexagonal nanoparticle with a diameter range of 11–25 nm in Ocimum tenuiflorum leaf extract [39]. Figure 3 shows SEM and EDX images of synthesized zinc oxide nanoparticles. The SEM images show agglomerations of individual zinc oxide particles. A closer look at the agglomerated lump shows the presence of several nanoparticle aggregates. In figure 3(a) particles appear to be agglomerated and some individual crystals are clearly visible. In figure 3(b), some particles appear to be elongated, hexagonal and rod-shaped. The EDX results shown in figure 3(c) further confirm the presence of zinc nanoparticles of oxide form, showing that the biosynthesis of ZnO nanoparticles serves as an effective means of processing.
Figure 3. SEM images at different magnitudes (a) and (b), and EDX spectrum (c) of ZnO nanoparticles.
Download figure:
Standard image High-resolution image3.4. TEM and SAED analyses
Figure 4 shows the sizes and morphologies of nanoparticles analyzed based on TEM and SAED patterns. The images (figure 4) show that the nanoparticles are hexagonal, rod-shaped or spherical at different nanometer scales. The presence of halo rings suggests that some parts of these particles are amorphous. The presence of spherical particles is attributed to the presence of an amorphous phase, which has no crystallographic orientation. Hexagonal molecules and biomolecules cap the zinc oxide particles. Similar hexagonal molecules have been observed in Euphorbia jatropha plant syntheses of zinc oxide nanoparticles [40]. The SAED pattern observed shows diffraction rings of the synthesized ZnO show Debye–Scherer rings at (1 0 0), (0 0 2), (1 0 1), (1 0 2), (1 1 0), (1 0 3), (2 0 0), (1 1 2), (2 0 1), (0 0 4), (2 0 2), (1 0 4) and (2 0 3) and lattice planes of the face centered cubic (fcc) ZnO, indicating that biogenic nanoparticles presented in the TEM images are nano-crystalline as shown in figures 4(a)–(c). The biomolecules affected the formation of ZnO nanoparticles. The particle size determined from the TEM analysis is in good agreement with that of the XRD analysis. The average size of the particles and the size distribution of the synthesized zinc oxide nanoparticles were determined using a particle size analyzer and corresponding results are shown in figure 5. The resulting particle size of the zinc oxide nanoparticles reflects a size distribution of 20–80 nm. An average particle size of 40 nm is found in agreement with scanning electron microscopy analysis results.
Figure 4. (a)–(c) TEM images at different scale bar, and (d) SAED image of ZnO nanoparticles.
Download figure:
Standard image High-resolution imageFigure 5. Size distribution of ZnO nanoparticles obtained from SAED.
Download figure:
Standard image High-resolution image3.5. Potential mechanisms of zinc oxide nanoparticles
Scheme 1 shows potential mechanisms of the formation of zinc oxide nanoparticles. Diosgenin, an aglycone, is a steroidal sapogenin that is commonly used as a raw material for the synthesis of steroidal drugs and especially for sex hormones, such as progesterone, testosterone, dihydroandrosterone, deoxycorticosterone and cortisone [41]. Dasgupta and Pandey [42] found diosgenin to be the main constituent isolated from rhizomes of Costus species. The diosgenin compound has also been found in the leaves, stems and flowers of costus plants [43]. We suggest that diosgenin, (C27H42O3) a phytosteroid sapogenin, is responsible for the formation of zinc oxide nanoparticles. When diosgenin combines with a metal nitrate, it forms a complex (e.g. a metal–diosgenin complex) via weak hydrogen bonds. This complex solution is then placed in an oven at high temperatures for 8 h and is converted into hydroxide forms. The biosynthesized hydroxide complex material undergoes calcination to form metal oxide nanoparticles. Although many other phytocompounds have been found in costus pictus leaf extracts, we used a diosgenin compound because it easily attracts metals due to its phenolic content. Earlier studies suggest that it is difficult to determine the exact mechanism and formation of nanoparticles due to the several phytocompounds present in plant extracts. Recent studies have predicted exact mechanisms involved using plant extracts. In this work we determine the mechanism that drives the synthesis of zinc oxide nanoparticle formation.
Scheme 1. Plausible ZnO nanoparticle formation mechanism.
Download figure:
Standard image High-resolution image3.6. Antimicrobial activity of ZnO nanoparticles
Kumari et al [44] found good antibacterial activity in Ag nanoparticles synthesized of Cordia dichotoma leaf extract against E. coli and Pseudomonas aeruginosa at different concentrations. Similarly, silver nanoparticles synthesized using different plant leaf extracts such as Xanthium strumerium L. and alkalized lemon grass also exhibited good antibacterial behavior [45, 46]. Govindappa et al [47] found some excellent antibacterial activity of silver nanoparticles against the bacterial species such as E. coli, P. aeruginosa, S. aureus and fungal species Fusarium semitectum, Penicilium species. In this study we explored antimicrobial activity of ZnO nanoparticles synthesized using medicinal plant costus pictus leaf extract. The antimicrobial activities of ZnO nanoparticles in contact with bacteria and fungi are shaped by particle sizes, morphologies, and specific surface areas involved. Manuela Stan and colleagues observed the antibacterial activities of plant extracts, such as Allium sativum, Rosmarinus officinalis and Ocimum basilicum [48]. Their study results show that green synthesized ZnO nanoparticles exhibit strong levels of bactericidal activity against S. aureus, B. subtilis, E. coli, and Salmonella typhimurium bacterial strains. We also found biosynthesized zinc oxide nanoparticles obtained from Costus pictus leaf extract to exhibit good antibacterial behavior. Figure 6 shows the antibacterial activity of the biosynthesized ZnO nanoparticles. Antibacterial activity was measured against two grams of positive bacteria (S. aureus, B. subtilis) and two gram of negative bacteria (E. coli, S. paratyphi). Ciprofloxacin is taken as the standard for all bacterial strains. A graph of levels of ZnO nanoparticle protection against the bacterial strains is shown in figure 7. Table 2 shows inhibition results obtained for the ZnO nanoparticles. To analyze antimicrobial behaviors, 100 µg/disc samples of bacterial and fungal strains were collected. Table 2 shows zones of inhibition for standard ciprofloxacin and for two gram positive bacteria of 32 mm (S. aureus) and 40 mm (B. subtilis). When we compare the zone of inhibition of two gram positive bacteria, B. subtilis (17 mm) shows a larger zone of inhibition compared to bacterial species S. aureus (10 mm). The zone of inhibition for standard ciprofloxacin for two gram negative bacteria ranges from 36 mm (E. coli) and 36 mm (S. paratyphi). A comparison of zone inhibition values for two gram negative bacteria S. paratyphi (12 mm) shows a larger zone of inhibition than that of negative bacterial strain E. coli (10 mm). Our observance of an inhibition zone clearly shows that the biosynthesized ZnO nanoparticles disrupt the membrane with high rates of surface oxygen species generation and finally cause the death of pathogens. Inhibition zones varied according to types of pathogens involved, synthesis methods applied and concentrations of ZnO nanoparticles used. We found that by increasing concentrations of ZnO nanoparticles discs, growth inhibition was consistently improved due to a proper diffusion of nanoparticles in the agar medium [49]. As another benefit, because the synthesized nanoparticles were smaller than bacteria pores, they could cross the cell membrane freely [50].
Table 2. Antibacterial results for the ZnO nanoparticles.
| Organism | Zone of inhibition (mm) | |
|---|---|---|
| Standard ciprofloxacin (10 µg/disc) | Samples (100 µg/disc) | |
| Insulin-ZnO | ||
| S. aureus | 32 | 10 |
| B. subtilis | 40 | 17 |
| E. coli | 36 | 10 |
| S. paratyphi | 36 | 12 |
Figure 6. Antibacterial image of ZnO nanoparticles (a) S. aureus (b) B. Subtilis (c) E. coli (d) S. paratyphi. (In-ZnO is insulin-ZnO, Std is standard.)
Download figure:
Standard image High-resolution imageFigure 7. Percentage of inhibition results against bacterial strains.
Download figure:
Standard image High-resolution imageTable 3 shows antifungal results for the biosynthesized ZnO nanoparticles. Figure 8 shows antifungal images of the ZnO nanoparticles protecting against two strains. The zone of inhibition for the standard fluconazole of two fungal species includes C. albicans (37 mm) and A. niger (30 mm). A. niger (16 mm) presents a larger zone of inhibition compared to those of the other fungal species C. albicans (12 mm) for the synthesized ZnO nanoparticles. Figure 9 shows graphic results for fungal species defending against the ZnO nanoparticles. Antifungal activity is likely derived through electrostatic attraction between the negatively charged cell membranes of microorganisms and the positively charged nanoparticles [51, 52]. The antimicrobial behaviors of biosynthesized zinc oxides using Costus pictus leaf extracts effective protect against bacterial and fungal species. Thus, nanoparticles can be used as antifungal agents and can help overcome hurdles of fungal disease management posed by the development of resistance to conventional fungicides.
Table 3. Antifungal results for the ZnO nanoparticles.
| Organism | Zone of inhibition (mm) | |
|---|---|---|
| Standard fluconazole (10 µg/disc) | Samples (100 µg/disc) | |
| Insulin-ZnO | ||
| C. albicans | 37 | 12 |
| A. niger | 30 | 16 |
Figure 8. Antifungal image of ZnO nanoparticles: (a) C. albicans and (b) A. niger. (In-ZnO is insulin-ZnO, Std is standard.)
Download figure:
Standard image High-resolution imageFigure 9. Percentage of Inhibition of fungal species.
Download figure:
Standard image High-resolution image3.7. Anticancer activity
Prasannaraj et al [53] found potential anticancer activity of silver nanoparticles synthesized using different plant extracts at different concentration against Hep-G2 and PC3 cancer cell lines. On the other hand, Ebrahiminezhad [54] found excellent anticancer activity of silver nanoparticles synthesized using microalgae Chlorella vulgaris in Hep-G2 cell line. In this work we focus on ZnO nanoparticles synthesized using costus pictus leaf extract and their potential anticancer behavior against the mice cell lines. Figure 10 shows anticancer images of ZnO nanoparticles at different concentrations. DLA bearing mice of cell lines is used based on different concentrations (10, 20 and 50 µg) of ZnO nanoparticles. The cyclophosphamide drug is taken as a standard for the DLA cell line. Figure 10(a) shows a control image wherein no inhibition effect is shown. However, in figures 10(b)–(d) we clearly observe a gradual increasing percentage of ZnO nanoparticle inhibition. Table 4 shows the anticancer activity of ZnO nanoparticles. These results imply that as concentrations increase from 10 µg to 50 µg, inhibition and cell viability levels also increase. At 50 µg we observe the maximum inhibition rate for ZnO nanoparticles. In this work we found biosynthesized ZnO nanoparticles to exhibit strong anticancer activity relative to other previously observed anticancer results [55].
Table 4. Anticancer activity results for the cell line DLA and ZnO nanoparticles.
| Concentration (µg/ml) | Inhibition (%) |
|---|---|
| Control | 99.90 |
| 10 | 24 |
| 20 | 40 |
| 50 | 48 |
Figure 10. Anticancer images of ZnO nanoparticles: (a) control, (b) 10 µg, (c) 20 µg and (d) 50 µg.
Download figure:
Standard image High-resolution image4. Conclusions
The biocompatible synthesis of zinc oxide nanoparticles (ZnO) was achieved by applying a simple and novel green chemistry procedure involving the use of Costus pictus leaf extract as a reducing and capping agent. The biosynthesis of ZnO nanoparticles was carried out via hydroxide precipitation at room temperature followed by calcination at 450 °C. The successful formation of zinc oxide nanoparticles was confirmed by FTIR, XRD, SEM, EDX, TEM and SAED analyses. XRD results confirms the average crystallite size observed from the intense plane of (1 0 1) was measured as 29.11 nm. The biosynthesized ZnO nanoparticles exhibited strong levels of antibacterial activity against B. subtilis (gram positive bacteria) and S. paratyphi (gram negative bacteria). A. niger exhibited stronger antifungal behavior than the C. albicans strain. Biosynthesized ZnO nanoparticles were found to protect against bacterial and fungal phyto pathogens, suggesting that they may be used as effective antimicrobial and anticancer agents for commercial biomedical applications.
Acknowledgments
This research was supported by the Future Material Discovery Program of the National Research Foundation of Korea (NRF) funded by the Ministry of Science, ICT and Future Planning (MSIP) of Korea (2016M3D1A1023532).